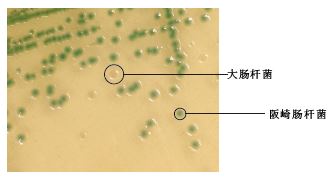

阪崎肠杆菌显色培养基是青岛海博生物公司根据GB/T4789.40生产的培养基,用于婴儿配方奶粉和其它食品中阪崎肠杆菌的快速检测。阪崎肠杆菌显蓝-绿色菌落,其它菌显无色或黄色。
成份(g/L)
|
胰蛋白胨
|
15.0
|
|
大豆蛋白胨
|
5.0
|
|
氯化钠
|
5.0
|
|
柠檬酸铁铵
|
1.0
|
|
硫代硫酸钠
|
1.0
|
|
脱氧胆酸钠
|
1.0
|
|
5-溴-4-氯-3-吲哚-α-D-吡喃葡糖甙
|
0.1
|
|
琼脂
|
15.0
|
|
pH 7.3±0.2 25℃
|
此配方可以进行改良或增加营养成份以获得最佳的结果。
用法:
称取本品8.62g,加入200ml蒸馏水,加热煮沸完全溶解,121℃高压灭菌15min,冷至50℃左右时,倾入无菌平皿。
原理:
利用阪崎肠杆菌自身代谢产生的酶与相应显色底物反应使菌落显色,以区分目标菌与非目标菌。显色底物是由产色因子和微生物部分可代谢物质组成,在特异性酶作用下,游离出产色因子使菌落显示一定颜色。
操作步骤:
1. 用接种环接种mLST-Vm肉汤或EE肉汤增菌液10μL划线或涂布于阪崎肠杆菌显色平板上;
2. 倒置放入培养箱36±1℃培养22-26h,典型的克罗诺杆菌为蓝-绿色菌落;
3. 挑取典型菌落做生化试验。
质量控制
1.外观
此干燥培养基的粉末均匀,具有良好的流动性,呈淡黄色或乳白色。制备好的平板呈淡黄色固体。
2.微生物试验:
在36±1℃培养22-26小时:
|
质控菌株
|
ATCC
|
生长情况
|
菌落颜色
|
|
阪崎肠杆菌
|
29544
|
+++
|
蓝-绿色
|
|
金黄色葡萄球菌
|
25923
|
-
|
-
|
|
沙门氏菌
|
13076
|
+++
|
无色,有黑色中心
|
|
大肠杆菌
|
25922
|
+++
|
淡黄色
|
|
肺炎克雷伯氏菌
|
10031
|
+++
|
无色
|
典型特征
典型的阪崎肠杆菌为蓝-绿色菌落,其它菌为无色、乳白色或黄色菌落。
贮存
制备好的平板可保存2-5天,应避免光线直接照射。干燥培养基应放置于阴暗干燥处,保存温度2-8℃,注意避光保存。
失效
干燥培养基超过保质期、结块和颜色变化都不能使用。
注意
此培养基仅供实验室使用。
查看我公司所有显色平板菌落特征,请点击:
显色平板菌落特征
克罗诺杆菌(阪崎肠杆菌)显色培养基(干粉)微生物灵敏度试验:
按标签用法制备培养基,接种以下质控菌株,放置36±1℃需氧培养22-26小时。

相关文章:
阪崎肠杆菌显色培养基(DFI琼脂) 点击查看
阪崎肠杆菌显色培养基(DFI琼脂)说明书 点击查看
GB 4789.40-2024 食品安全国家标准 食品微生物学检验 克罗诺杆菌检验 点击查看


 海博微信公众号
海博微信公众号
 海博天猫旗舰店
海博天猫旗舰店


 海博微信公众号
海博微信公众号
 海博天猫旗舰店
海博天猫旗舰店






